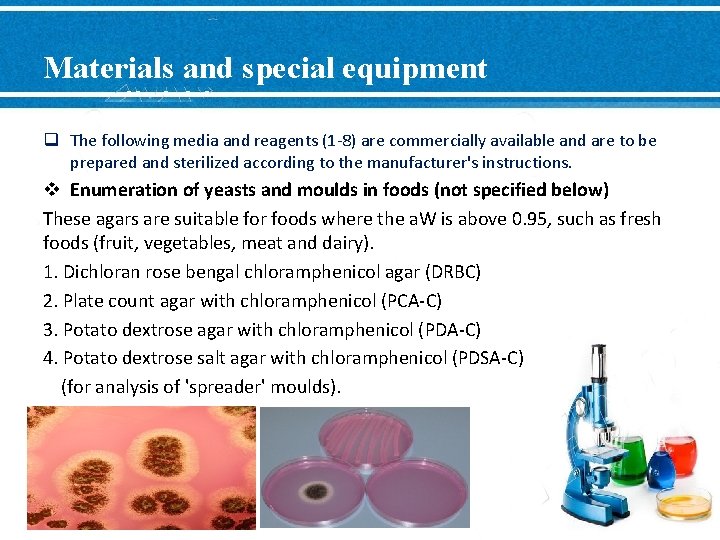

Lab 5 Enumeration of yeasts and moulds in

Lab 5: Enumeration of yeasts and moulds in foods

Fungi Larger Eukaryotic Aerobic Slow growth Grow in both acidic and basic condition Filamentous Mycelia v Fungi kingdom (yeasts and molds) -Subkingdom: based on septation of mycelia - Phylum: based on ability to produce and type of sexual spores Molds Yeasts unicellular multicellular non-filamentous

Enumeration of yeasts and moulds in foods v Application • This method is applicable to the enumeration of viable yeasts and moulds in foods and food ingredients. • It may also be used to confirm the viability of apparent yeast and mould material scraped from food plant equipment and the manufacturing environment.

Media v Acidified Potato Dextrose Agar § PDA (nonselective) + tartaric acid • low p. H inhibits most bacteria & permits growth of fungi. • Note: Some acid-tolerant bacteria can still grow leading to an over-estimate of fungi count

Media v. Antibiotic Plate Count Agar § PCA (nonselective) + antibiotics (chloramphenicol & tetracycline) • antibiotics prevent bacterial growth by inhibiting protein synthesis

Media v Petrifilm (for Yeasts & Molds) -nutrients +antibiotics + indicator dye -Selective and differential for yeasts and molds - Contain chlortetracycline and chloramphenicol - Indicator: bromo-chloro-indolylphosphate gives yeast a blue-green color. - Yeasts: small and defined - Molds: larger and diffuse

Media preparation 1. Label empty plates 3. Pour plates PCA PDA Antibiotic Tartaric acid 50 C 2. Add selective agents 2 ml Ab-PCA 1. 85 ml Acid-PDA

Y/M period 2 Mon, Oct 7 1 ml Peptone water 9 ml 100 10 -1 10 -2 Acidified PDA 0. 1 ml each Antibiotics PCA Y/M petrifilm 1 ml each

Defination of terms v Scrapings: Suspected yeast and mould material scraped from food plant equipment and the manufacturing environment. v Xerophilic: Moulds capable of growing at reduced water activity (aw). (Yeasts preferring reduced aw are also sometimes referred to as xerophilic. ) v Osmophilic: Yeasts preferring high osmotic pressures for growth.
Materials and special equipment q The following media and reagents (1 -8) are commercially available and are to be prepared and sterilized according to the manufacturer's instructions. v Enumeration of yeasts and moulds in foods (not specified below) These agars are suitable for foods where the a. W is above 0. 95, such as fresh foods (fruit, vegetables, meat and dairy). 1. Dichloran rose bengal chloramphenicol agar (DRBC) 2. Plate count agar with chloramphenicol (PCA-C) 3. Potato dextrose agar with chloramphenicol (PDA-C) 4. Potato dextrose salt agar with chloramphenicol (PDSA-C) (for analysis of 'spreader' moulds).

Materials and special equipment Enumeration of xerophilic yeasts and moulds in grains, flours, nuts, and spices 5. Dichloran-glycerol DG 18 agar (DG-18) Enumeration of xerophilic yeasts and moulds in jams, jellies, fruit concentrates, and dried fruits 6. 20% sucrose (diluent additive for osmophiles) 7. Malt extract agar containing 50% (w/w) sucrose

Materials and special equipment Other: 8. Peptone water (0. 1%) (PW) 9. 2% sodium citrate tempered to 45 o. C (diluent for high fat foods, such as cheese) (optional) 10. 1 N HCl and 1 N Na. OH 11. Gram stain solutions 12. Stomacher, blender or equivalent 13. p. H meter or paper capable of distinguishing to 0. 3 to 0. 5 p. H units within a range of 5. 0 to 8. 0 14. Light microscope 15. Colony counting device (optional) 16. Incubator (darkened) capable of maintaining 22 to 25 o. C, 55 o. C water bath (and 45 o. C water bath if sodium citrateistobeused).

Procedure v Each sample unit shall be analyzed individually. v The test shall be carried out in accordance with the following instructions: q Handling of Sample Units and Scrapings 1. During storage and transport, the following shall apply: with the exception of shelf- stable products, keep the sample units refrigerated (0 -5 o. C). Sample units of frozen products shall be kept frozen. 2. Thaw frozen samples in a refrigerator or under time and temperature conditions which prevent microbial growth or death. 3. Analyze the sample units as soon as possible after receipt at the laboratory.

Procedure q Preparation of Medium 1. Prepare the appropriate media for the analysis being carried out. NOTE: DRBC agar should not be exposed to light, since photo-degradation of rose bengal produces compounds that are toxic to fungi. 2. Temper melted agar in a 55 o. C water bath, ensuring that the water level is 1 cm above the level of the medium in the bottles. 3. Clean surface of working area with a suitable disinfectant. 4. Mark clearly the duplicate petri plates identifying sample, sample unit, dilution and date of inoculation.

Procedure q Preparation of Dilutions 1. Prepare 0. 1% peptone water as diluent. • An appropriate solute, such as 20% sucrose, should be added to the diluent when enumerating osmophiles in foods such as syrups and fruit juice concentrates. • In addition, a 2% solution of sodium citrate, pre-warmed to 45°C, can be used as diluent for high-fat foods such as cheese. 2. To ensure a representative analytical portion, agitate liquid or free flowing materials until the contents are homogeneous. • If the sample unit is a solid, obtain the analytical unit by taking a portion from several locations within the sample unit.

Preparation of Dilutions 3. Some degree of soaking may be beneficial for the recovery of yeasts and moulds from dried or intermediate-moisture foods. • Soaking may allow for the repair of sub-lethally damaged cells (resuscitation). • Rehydrate dried foods for 1 h with an equal amount of distilled water or peptone water and store at room temperature. 4. Prepare a 1: 10 dilution of the food by aseptically blending 25 g or m. L (the analytical unit) into 225 m. L of the required diluent, as indicated in Table I. • If a sample size other than 25 g or m. L is used, maintain the 1: 10 sample to dilution ratio, such as 11 (10) g or m. L into 99 (90) m. L.

Preparation of Dilutions 5. Stomach, blend or shake according to the type of food. • Blend or stomach for the minimum time required to produce a homogeneous suspension. • To prevent over-heating, blending time should not exceed 2. 5 min. • With foods that tend to foam, use blender at low speed and remove aliquot from below liquid/foam interface. 6. Verify the p. H of the suspension. If the p. H is not between 5. 5 and 7. 5, adjust the p. H to 7. 0 with a sterile solution of 1 N Na. OH or 1 N HCl.

7. If the 1: 10 dilution is prepared in a dilution bottle, it should be mixed by shaking the bottle 25 times through a 30 cm arc in approximately 7 sec. 8. Prepare succeeding decimal dilutions as required, using a separate sterile pipette for making each transfer. 9. Because mould prop gules may settle out within a few minutes, it is important to shake all dilutions immediately prior to making transfers to ensure uniform distribution of the microorganisms present.

Plating 1. Agitate each dilution bottle to resuspend material that may have settled out during preparation. 2. Moulds should be enumerated by a surface spread-plate technique rather than with pour plates. • This technique provides maximal exposure of the cells to atmospheric oxygen and avoids heat stress from molten agar. • Agar spread plates should be dried overnight before being inoculated. • Spread 0. 1 m. L onto duplicate plates. 3. For determination of viability of suspected yeast and mould material from food plant equipment and the manufacturing environment, aseptically tease the scrapings apart and distribute the pieces over the surface of solidified medium.

Incubation • Incubate plates undisturbed in an upright position at 22 to 25 o. C for 3 -5 days. • Incubate plates in the dark. • Normally, count colonies on plates after 5 days. • Handle the plates as little as possible when counting on day 3 so spores will not be dislodged, which may result in secondary growth.

Counting Colonies and Examining Growth 1. Count colonies, distinguishing, if required, yeast colonies from mould colonies, according to their colonial morphology. • Microscopic examination with crystal violet stained smears may be necessary to distinguish yeast colonies from some bacterial colonies that may look like yeast. 2. If possible, select plates with 10 -150 colonies. • Determine the identity of pin-point colonies microscopically. • If counts do not fall within this range, select plates that fall nearest to the 10 -150 range.

Counting Colonies and Examining Growth 3. If plates contain colonies which spread, select a representative portion of the plates free from spreaders, if possible, and count colonies in this area. • The total count of the whole plate is estimated by multiplying the count for the representative area by the reciprocal of the fraction of the plate counted, e. g. , 30 colonies counted on 1/4 of the area of the plate; count for the whole plate: 30 x 4 = 120 colonies. • Results are expressed as an estimated count. 4. Wet mounts and gram stains of several diverse types of cells per sample should be examined to confirm that bacteria are not present. • Yeast cells and asexual mould spores are generally gram-positive, whereas mould mycelia are gram-negative.

Table 1 Type of Food Preparation* Treatment Liquids: milk, water etc. pipette directly into Petri dishes and/or into peptone water diluent Shake viscous lipids weigh into peptone water diluent Shake Water Solids soluble weigh into peptone water diluent Shake powder, meats weigh into peptone water diluent Stomach or Blend powder, meats weigh into previously warmed (45 o. C) 2% sodium citrate(Na 3 C 6 H 5 O 7. 2 H 2 O) Stomach or Blend Spices weigh into diluent Shellfish weigh into peptone water diluent Solids: Shake Stomach or Blend Note/ *Sample may be weighed into a stomacher or blender jar with the diluent added prior to mixing.

END OF LECTURE
- Slides: 24